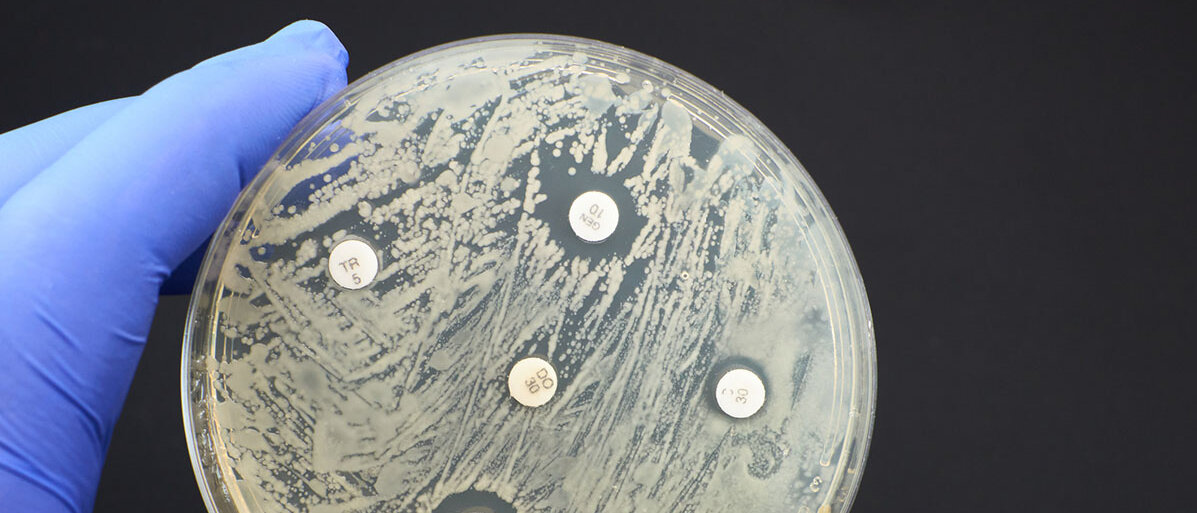

Antimikrobielle Resistenzen
WHO DRÄNGT AUF IMPFSTOFFENTWICKLUNG
Seite 1/1 1 Minute
Sie drängte Geldgeber am Dienstag, Studien zu Impfstoffen zu beschleunigen und zu prüfen, wie bereits vorhandene Impfstoffe besser eingesetzt und vor allem weltweit verteilt werden können. Mit Impfungen sollen die Infektionen von vornherein verhindert werden.
Von antimikrobiellen Resistenzen (AMR) spricht man, wenn etwa Bakterien aufgrund von genetischen Veränderungen nicht mehr auf eigentlich wirksame Medikamente ansprechen. Auch Pilze, Parasiten und Viren können Resistenzen entwickeln. Infektionen mit diesen Erregern können dann sehr schwer oder sogar tödlich verlaufen. Die WHO spricht von einer "stillen Pandemie", die im Jahr mindestens 1,27 Millionen Menschen direkt das Leben kostet. Insgesamt geht sie von 4,95 Millionen AMR-Todesfällen aus. Dabei geht es um Menschen, deren Behandlung durch eine Resistenz erschwert wird und die dann an anderen Komplikationen sterben.
Entwicklung neuer Imfpstoffe vorantreiben
Besorgniserregende Resistenzen entwickeln sich vor allem, wenn Antibiotika nicht korrekt eingenommen werden: zu häufig, zu kurz oder falsch dosiert. Das fördert die Selektion von eben solchen Bakterien, die eine Resistenz entwickelt haben. Sie vermehren und verbreiten sich dann.
Die WHO hat eine Prioritätenliste mit zwölf resistenten Bakterien, gegen die dringend Antibiotika entwickelt werden müssten. Es gebe zwar 61 Impfstoffkandidaten, aber keiner davon werde in absehbarer Zeit zur Verfügung stehen. Keiner betrifft auch die drei Bakterien, die am meisten Todesfälle verursachen: die als Krankenhauskeime bekannten Acinetobacter baumannii, Pseudomonas aeruginosa und bestimmte Erreger aus der Gruppe der Enterobacteriaceae. Die Coronavirus-Pandemie habe gezeigt, dass neue Impfstoffe schnell entwickelt werden können, so die WHO. Die gewonnenen Erkenntnisse müssten nun auch bei AMR genutzt werden.
Quelle: dpa